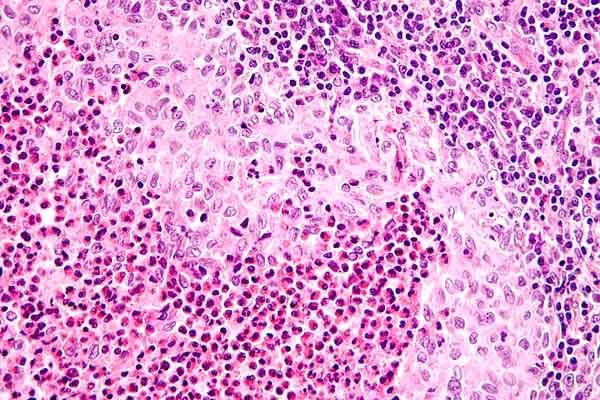

¿Qué son las células de Langerhans?
Las células de Langerhans son un grupo de células del sistema inmunológico de los mamíferos con una amplia presentación de antígenos. Se encuentran principalmente en tejidos expuestos al ambiente externo, como la piel. Sin embargo, también pueden hallarse en el timo o las amígdalas, entre otros lugares.
Forman parte de las llamadas células dendríticas. Fueron descubiertas en 1868 por el entonces estudiante alemán de medicina, Paul Langerhans, de donde proviene su nombre. Fueron las primeras células dendríticas descritas.
Se diferencian de otras células semejantes por la presencia de orgánulos o cuerpos de Birbeck. La función principal de estas células es la de absorber y procesar agentes externos, dando inicio y regulación a la respuesta inmune.
Las células de Langerhans (a partir de ahora, CL) son una de las variedades de células dendríticas conocidas, aunque algunos autores las clasifican a todas como iguales. Por otra parte, las CL no deben confundirse con los islotes de Langerhans ni con las células gigantes de Langerhans.
Características de las células de Langerhans
- Son células presentadoras de antígenos. Se caracterizan principalmente por tener orgánulos citoplasmáticos, llamados cuerpos de Birbeck.
- Se localizan en todas las capas epidérmicas (piel), y son más prominentes en el estrato espinoso, es decir, entre el estrato granuloso y basal de la epidermis.
- Ubicación en otros tejidos. También están en tejidos como ganglios linfáticos, en la membrana que recubre la cavidad bucal, amígdalas, el timo, la vagina y el prepucio. Estas células tienen la particularidad de extender sus procesos membranosos entre las células epiteliales, sin alterar el óptimo funcionamiento de la barrera epitelial.
- Aparición. Se originan en el organismo a partir de la semana 14 del desarrollo embrionario. Una vez que aparecen, ocupan la epidermis y el resto de los tejidos antes mencionados. Dentro de ellos se replican y cumplen su ciclo en un tiempo aproximado de 16 días.
- Densidad. Las CL representan, en un humano sano, aproximadamente el 4% del total de las células de la epidermis. Su distribución y densidades varían de un sitio anatómico a otro. Se calcula que en la epidermis pueden llegar a existir desde 400 hasta 1.000 células de Langerhans por milímetro cuadrado.
Morfología de las células de Langerhans
Cuando se realizan ensayos de tinción de células de Langerhans, y se observan empleando un microscopio electrónico, se puede ver que están separadas de los queratocitos (células predominantes de la epidermis) por una hendidura.
También se pueden observar los característicos cuerpos de Birbeck, que tienen forma de bastón, raqueta de tenis o de ampolla hemisférica en un extremo de una estructura recta y plana.
Existe un grupo de células idénticas a las células de Langerhans, pero que no tienen los cuerpos de Birbeck. A estas se les llama “células indeterminadas”. Los científicos consideran que una proteína llamada lectina, junto a otros factores, son los responsables de la formación de dichos gránulos o cuerpos.
Las células de Langerhans son similares a otros macrófagos. Sin embargo, exhiben una variada morfología, dependiendo de si son inmaduras, maduras o si han capturado un antígeno.
Células inmaduras
Durante su estado inmaduro, muestran una morfología estrellada, con muchas vesículas. Llegan a medir unas 10 micras.
Células maduras
En la etapa madura, pueden llegar a tener una variedad de procesos membranosos (en la membrana plasmática). Estas pueden tener formas de dendritas, de velo o poseer pseudópodos.
Un ejemplo de estos procesos membranosos es la forma de velo. Esta se forma luego de que la célula captura un antígeno durante una infección. A partir de ese momento, la morfología dendrítica cambia a proyecciones de la membrana plasmática parecidas a un velo.
Funciones de las células de Langerhans
- Las CL cumplen la función en el organismo de capturar y procesar antígenos. Estas células pueden llegar a trasladarse desde la piel hasta el tejido linfoide, y cuando llegan allí comienzan a interactuar con los linfocitos (células T), para iniciar la respuesta inmune adaptativa.
Histología de las células de Langerhans
La histología es una rama de la biología que estudia la composición, crecimiento, estructura y características de los tejidos de todos los organismos vivos. En el caso de las células de Langerhans, se hará referencia al tejido epitelial animal, en especial al de los seres humanos.
- Epidermis. Las células de Langerhans están en la epidermis. En esta fina capa de la piel, representan una pequeña porción respecto a células predominantes, como los queratocitos. También comparten el epitelio con otros dos tipos de células, llamadas melanocitos y células de Merkel.
- Dermis. También están presentes en la dermis, otra capa de la piel. A diferencia de lo que ocurre en la epidermis, aquí las CL están acompañadas por otro grupo diferente de células, llamadas mastocitos, histiocitos, fibrocitos y dendrocitos dérmicos.
Enfermedades asociadas a las células de Langerhans
Enfermedades de transmisión sexual
Aun cuando las células de Langerhans tienen la función de capturar y procesar antígenos, existe un gran debate al respecto de su efectividad como barrera contra enfermedades de transmisión sexual, causadas por virus como el VIH o el VPH (virus de papiloma humano).
Algunos investigadores sugieren que estas células pueden llegar a ser reservorios y hasta vectores de diseminación de dichas enfermedades, pero, por otra parte, otros han evaluado la eficiencia de la proteína langerin, presente en CL y otros macrófagos, señalándola como una barrera natural exitosa en contra de enfermedades como el VIH-1.
Histiocitosis de células de Langerhans
Es un muy raro tipo de cáncer que se atribuye a la proliferación de células de Langerhans anormales. Estas células provienen de la médula ósea y pueden llegar a desplazarse desde la piel hasta el nodo o ganglio linfático.
Los síntomas se manifiestan como lesiones óseas hasta enfermedades que afectan otros órganos, incluso al organismo en general.
El diagnóstico de la enfermedad se realiza mediante una biopsia de tejido. En esta deberán aparecer CL con características muy diferentes a las habituales, como por ejemplo, citoplasma granular con coloración rosada y margen celular diferente al normal.
Como tratamiento para esta enfermedad se ha propuesto aplicar radiación de unos 5 a 10 Gray (Gy) en niños y de 24 a 30 Gy en adultos. En patologías sistémicas, por lo general se emplea quimioterapia y esteroides en crema sobre las lesiones cutáneas. La enfermedad tiene un alto índice de supervivencia, con un 10% de mortalidad.
Otras patologías
La exposición de la epidermis al ambiente externo y la gran variedad de factores que pueden afectar la correcta homeostasis, pueden desencadenar una baja eficiencia de las funciones de las células de Langerhans.
Esta baja eficiencia podría permitir la entrada al organismo, por vía epitelial, de parásitos, hongos, bacterias, sustancias alérgenas, entre otras, capaces de causar daños al individuo.
Usos de las células de Langerhans en medicina
Las células de Langerhans han sido empleadas de forma experimental, como moduladoras de la respuesta inmunitaria, bien sea para generar la respuesta, potenciarla o evitarla.
Tratamiento de melanomas
Se conoce un gran número de ensayos exitosos, tanto en animales como en seres humanos, en el tratamiento de melanomas (cáncer de piel). En estas pruebas, se han obtenido células de Langerhans de los mismos pacientes y se han estimulado bajo condiciones controladas.
Una vez que las CL se estimulan apropiadamente, son reimplantadas en el paciente para generar una respuesta inmune antitumoral. Los resultados de estas pruebas, según algunos autores, son bastante alentadores.
Tratamientos contra la Leishmania sp
Leishmania sp es un género de protozoario que causa la enfermedad cutánea conocida como leishmaniasis. Esta enfermedad se manifiesta con ulceraciones cutáneas que no cicatrizan de forma espontánea. Las manifestaciones críticas o fatales de la enfermedad muestran no solo las ulceraciones, sino inflamación del hígado y el bazo.
Un grupo de investigadores descubrió que se pueden insertar secuencias de ADN y/o ARN para modificar CL, con la finalidad de codificar y expresar antígenos de interés y producir sustancias que potencien la respuesta inmunitaria necesaria para luchar contra enfermedades como la leishmaniasis.
Otros tratamientos
Actualmente, existen ensayos para desarrollar y modificar células de Langerhans e incluso otras células dendríticas, para crear y potenciar las respuestas inmunes, no solo para melanomas y leishmaniasis, sino para alergias cutáneas e incluso enfermedades autoinmunes.
Por otra parte, vale la pena mencionar que se ha descubierto que la presencia de ciertos elementos químicos y compuestos, hallados en aguas termales y aguas de azufre, conocidas como aguas medicinales, mejora la respuesta inmune de las CL. Debido a ello, a veces son utilizadas en el tratamiento de la psoriasis y la dermatitis atópica.
Referencias
- Langerhans cell. Recuperado de en.wikipedia.org.
- Dendritic cell. Recuperado de en.wikipedia.org.
- Langerhans cell. Recuperado de decs.bvs.br.
- Embryologic, histologic, and anatomic aspects: Langerhans cells. Recuperado de derm101.com.
- Langerhans cell histiocytosis. Recuperado de en.wikipedia.org.